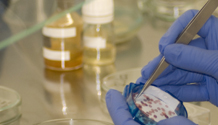
Laboratoires d’essais

Laboratoires d’analyses amiante, plomb, HAP, analyses de sols, pack ISDI et plus en Île-de-France
Laboratoires BJL, laboratoire indépendant à Sèvres (Île-de-France) : analyses amiante, analyses plomb, analyses HAP (enrobés bitumineux), analyses de sols et pack ISDI pour professionnels.
Laboratoires d’essais
- Mesure d’empoussièrement en fibres d’amiante dans les immeubles bâtis
- Mesure des niveaux d’empoussièrement en fibres d’amiante au poste de travail
- Analyse d’amiante dans tous les matériaux
- MOCP Fibres Céramiques Réfractaires (FCR)
- Analyse des HAP dans les enrobés bitumineux
- Lixiviation plomb
- Plomb dans l’eau
- Plomb dans l’air
- Plomb dans peinture
- Plomb dans poussières
- Analyses des sols
- MEST
Produits d’échantillonnages

Kits de prélèvement
- Lingettes plomb
- Sachets amiante
- Lingettes amiante
- Bocaux MEST
- Bocaux sols
- Cassettes amiante standard 37mm
- Cassettes amiante tête CATHIA
- Cassettes amiante Porteur
- Cassettes Plomb
Matériel de prélèvement
- Pompes prélèvements air amiante
- Pompes prélèvements air plomb
Prestations réalisées sous accréditation




















